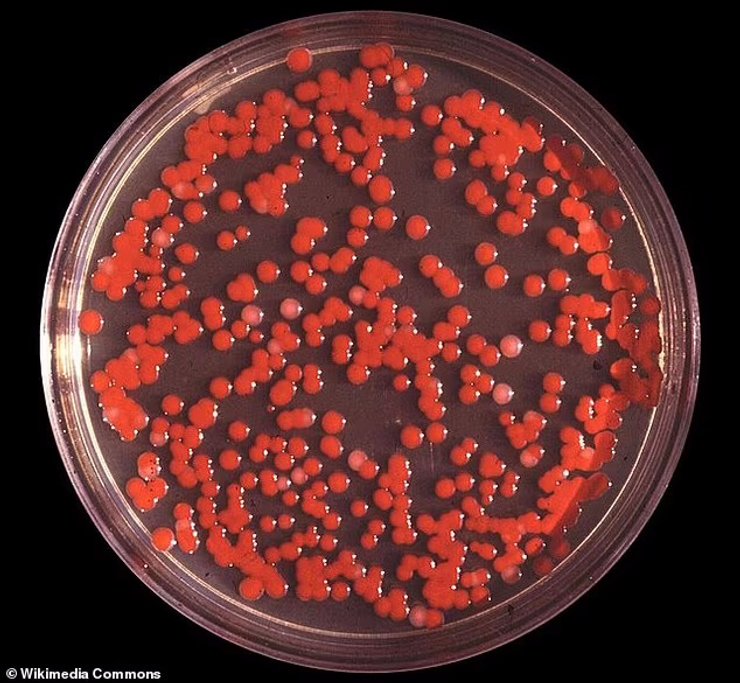
туман, секретний експеримент

Таємничий туман огорнув землю і налякав людей: побоюються біологічної зброї (фото)

Густий таємничий туман огорнув більшу частину цілої країни, викликавши страх перед новою секретною військовою програмою 1950 року.
Протягом одного тижня у вересні 1950 року ВМС США розпорошували величезну кількість бактерій у повітрі лише за 3 кілометри від узбережжя Сан-Франциско (Каліфорнія, США). Метою цього секретного експерименту з біологічної війни було з'ясування того, наскільки вразливими є великі американські міста, такі як Сан-Франциско, для біологічної атаки терористів, пише Daily Mail.
Тоді дослідники використовували бактерії Serratia marcescens, здатні спричиняти респіраторні проблеми та менінгіт, а також Bacillus atrophaeus, що можуть бути смертельними для людей з ослабленим імунітетом. Зазначимо, що на той час ВМС США вважали ці бактерії нешкідливими для людей.
У Фокус. Технології з'явився свій Telegram-канал. Підписуйтесь, щоб не пропускати найсвіжіші та найзахопливіші новини зі світу науки!
На жаль, після експерименту жителі узбережжя почали звертатися по медичну допомогу. Тоді стало зрозуміло, що вдихання тисячі спор бактерій вельми небезпечне: 11 осіб звернулися до лікарні з рідкісними й серйозними інфекціями сечових шляхів, які лікарі зрештою визначали як викликані експериментом.
З моменту експерименту минуло 75 років і тепер деякі американці побоюються, що це може статися знову, оскільки вони стверджують, що "неприродний" туман із "запахом, схожим на палений хімікат" переслідує і громади в останні тижні. Деякі свідки також стверджують, що туман викликав симптоми, схожі на респіраторне захворювання.
Деякі жителі Флориди, яким не пощастило опинитися на вулиці під час туману, розповідають, що всього за 10 хвилин його впливу їм стало погано. Приблизно через годину чхання продовжилося, а очі залишалися опухлими протягом приблизно трьох годин. Також свідок відчував жар, а його шлунок звело.
Зазначимо, що попередження про туман було випущено цього тижня одразу в кількох штатах. Зокрема: Техас, Вісконсин, Айова, Мериленд, Вірджинія, Західна Вірджинія, Небраска, Канзас, Оклахома, Північна Дакота, Флорида, Міннесота. Аналогічні випадки також сталися в деяких частинах Канади та Великої Британії, що викликало загальне занепокоєння.
У результаті в Мережі з'являється дедалі більше повідомлень про теорію змови. Люди побоюються, що туман може бути свого роду хімічною зброєю або пов'язаний з безпілотниками, які загадковим чином заполонили всю країну. Остання теорія полягає в тому, що за туманом стоїть уряд США, який потенційно випробовує новий тип біологічної зброї.
Водночас Національна метеорологічна служба (NWS) випустила попередження про густий туман для кількох штатів у той час, коли з'явилися ці повідомлення, що передбачає наукове пояснення туману.
Дослідники визнають, що зовнішній вигляд туману у вигляді "білих частинок" може здатися незвичним, це не зовсім так. Учені зазначають, що туман — видимий аерозоль, що складається з крихітних крапельок води або кристалів льоду, зважених у повітрі на поверхні Землі або біля неї. Простими словами, якщо підсвітити туман, ці частинки стануть видимими.
За словами атмосферного вченого з Вашингтонського університету Рудольфа Хусара, коли утворюється туман, оксиди сірки й азоту та інші забруднювальні гази поглинаються або "вимиваються" краплями води туману. Саме цим пояснюється і запах. Ба більше, запахи стають сильнішими у вологому повітрі, тому що краплі води утримують молекули, що спричиняють запах, і дають змогу їм затримуватися довше та залишатися концентрованими.
Раніше Фокус писав про те, де мешкають "Темні спостерігачі", і чому вони люблять туман.